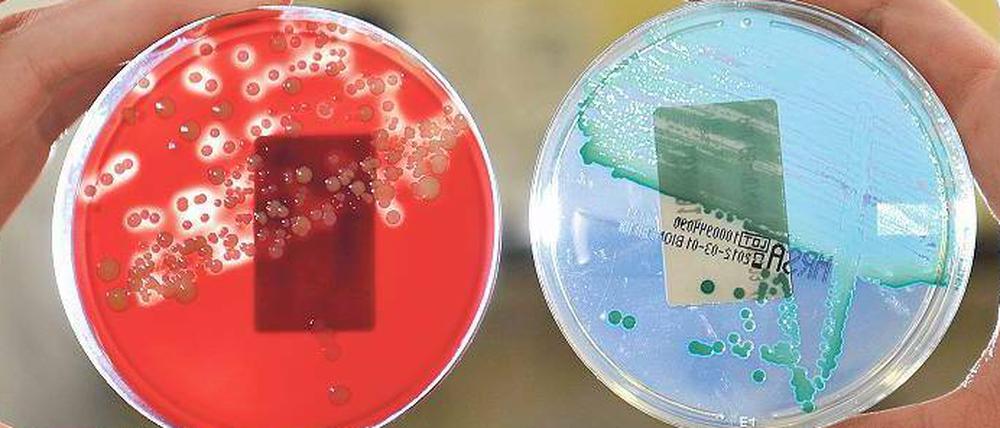

© dapd
Krankenhauskeime: Auf der Jagd nach dem Impfstoff
Krankenhauskeime sind gefährlich, Infektionen enden oft in tödlichen Komplikationen. Impfen könnte helfen. Doch bei der Suche nach einem Impfstoff stoßen Forscher auf zahlreiche Hindernisse.
Stand:
Die Krankengeschichte von Hans-Werner Röhlig ist typisch. Bei einer Herzkatheteruntersuchung wurde der Richter aus Gladbeck mit resistenten Bakterien, Staphylococcus aureus (MRSA), infiziert. Über drei Monate dauerte es, bis die Ärzte die Infektion in den Griff bekamen und sich die entzündete Wunde schloss. Dabei hatte Röhlig noch Glück. Oft enden die weltweit durch MRSA verursachten 1,5 Millionen Krankenhausinfektionen tödlich – etwa wenn die Bakterien bei geschwächten Patienten eine Lungenentzündung oder Blutvergiftung auslösen.
Damit nicht genug. Während sich Menschen bis vor einigen Jahren nur in der Klinik mit MRSA ansteckten, passiert das heute auch bei sonst gesunden Personen in ihrem alltäglichen Umfeld. „Antibiotika werden das Problem nicht lösen“, sagt Knut Ohlsen vom Institut für molekulare Infektionsbiologie an der Universität Würzburg. Ständig entstünden neue Stämme, die sich schnell ausbreiten. Ein Ausweg könnte ein anderer Ansatz sein: Eine Impfung oder Immuntherapie soll dem körpereigenen Immunsystem helfen, sich gegen die Staphylokokken zu wehren.
Die Idee ist da, doch die Umsetzung ist schwer. Klinische Tests mit Impfstoffen scheiterten bisher. So bildeten zwar hunderte Dialysepatienten Abwehrmoleküle gegen zwei Zuckerbausteine der äußeren Staphylokokken-Kapsel, mit denen sie geimpft worden waren (StaphVax). Doch später infizierten sie sich genauso oft mit S. aureus wie die Probanden der nicht geimpften Kontrollgruppe.
Die Fehlschläge haben verschiedene Gründe. Zum einen weiß man nur lückenhaft, wie das Immunsystem überhaupt auf eine S.-aureus-Infektion reagiert. Anders als bei anderen Krankheiten schützt eine durchgemachte Infektion jedoch nicht vor erneuter Ansteckung. „Es ist unklar, ob die Immunantwort wie Antikörper und Immungedächtnis überhaupt einen Schutz vor den Bakterien gewährleisten kann“, sagt Barbara Bröker vom Institut für Immunologie an der Universität Greifswald.
Im Laufe der Kindheit werde fast jeder Mensch von S. aureus besiedelt. Nach der Pubertät sinke der Anteil der Bakterien-Träger wieder, sagt die Immunologin. Die kugeligen Keime leben schließlich unauffällig auf der Haut oder Nasenschleimhaut von etwa 25 Prozent aller Erwachsenen. Nur hin und wieder zeigt der harmlose Mitbewohner sein zweites Gesicht. Als aggressiver Krankheitserreger kann er dann nicht nur Haut- und Weichteile befallen, Abszesse und Furunkel verursachen, sondern auch für lebensbedrohliche Lungenentzündungen und Sepsis sorgen. „Warum drei Viertel der Menschen die Bakterien nach kurzer Auseinandersetzung rasch wieder abschüttelten, weiß man nicht“, sagt Bröker. Genauso unbekannt sei, warum sich die Mikroorganismen unter gewissen Umständen zum aggressiven Keim wandelten.
Die Körperabwehr bekämpfe die Bakterien zwar, verhindere jedoch nicht, dass sie sich auf der Nasenschleimhaut niederlassen. Wahrscheinlich bewahre die Immunabwehr den betroffenen Menschen jedoch vor schwerwiegenden Komplikationen, wenn – möglicherweise über Jahre – ein solides Immungedächtnis aufgebaut wurde. Vermutlich könnte daher auch ein Impfstoff eine Infektion nicht gänzlich verhindern, sondern lediglich deren schwere, lebensbedrohliche Verläufe verhindern. Neben der komplizierten Immunologie gibt es auf dem Weg zu einem Impfstoff eine zweite Hürde: Bisher ist unklar, welche Bestandteile der Bakterien sich für eine Impfung eignen. Sinnvoll wäre, wenn die Impfstoffe eine Immunantwort gegen solche Moleküle auslösen könnten, über die die Bakterien Krankheitssymptome im menschlichen Körper auslösen. Einige Pharmafirmen arbeiten bereits an Impfstoffen, die neben anderen Bakterienbausteinen auch entschärfte Varianten solcher „Virulenzfaktoren“ enthalten. Der Impfstoff „PentaStaph“ soll unter anderem Antikörper gegen zwei „Fluchthelfer“ erzeugen, mit denen die Bakterien sonst die Angriffe von Fresszellen des Immunsystems abwehren.
Ob man mit Impfstoffen, die auf die Produktion schützender Antikörper setzten, den trickreichen Staphylokokken ernsthaft zu Leibe rücken kann, bezweifeln Experten. Um gegen den Spezialfall S. aureus vorzugehen, müsse man verschiedene immunologische Mechanismen aktivieren, sagt etwa Robert Daum, ein amerikanischer MRSA-Forscher von der Universität von Chicago.
Ihm war der Fall eines kranken Mädchens aufgefallen, das immer wieder in die Klinik eingeliefert wurde, weil es mit Staphylokokken kämpfte. Wie sich herausstellte, litt das Kind an einer genetisch bedingten Immunschwäche. Ihm fehlte eine bestimmte Gruppe von Immunzellen, die TH17-Zellen.
TH17-Zellen spielen offenbar eine wichtige Rolle bei der Kontrolle von Infektionserregern. Sie können zum Beispiel die Fresszellen des Immunsystems anlocken und zur Vernichtung von Bakterien anspornen. Robert Daum ist überzeugt, dass der Schlüssel zu einem wirksamen Staphylokokken-Impfstoff bei diesen TH17-Zellen liegt. „Wir kennen inzwischen Botenstoffe, die Impfstoffen beigemengt werden könnten, um die Immunantwort in Richtung TH17 zu lenken“, sagt Christina Zielinski, die in der Abteilung für Dermatologie und Allergie an der Berliner Charité erforscht, wie sich das Immunsystem mit Bakterien auseinandersetzt. „So kann man die Bekämpfung der Krankheitserreger unterstützen.“ Doch auch die Entwicklung eines solchen T-Zell-Impfstoffes sei keineswegs trivial, sagt die Medizinerin.
Knut Ohlsens Team von der Universität Würzburg geht einen anderen, direkteren Weg. Es setzt nicht auf eine aktive Impfung. Der Forscher will im Akutfall mit monoklonalen Antikörpern, die sich gegen bakterielle Proteine richten, schlimme Komplikationen einer Infektion verhindern. Vor einigen Jahren hatten die Forscher diese Antikörper im Blutserum von Patienten entdeckt, die eine Staphylokokken-Sepsis überlebt hatten. Inzwischen werden die Antikörper monoklonal hergestellt und schützen im Mausmodell vor einer Infektion: Sie unterstützen die Fresszellen des Immunsystems effektiv bei der Beseitigung der Bakterien. Erste klinische Tests am Menschen sollen in etwa zwei Jahren starten. Ist die Therapie auch dann noch erfolgreich, könnte sie immungeschwächten Neugeborenen oder alten Patienten mit einer Staphylokokken-Infektion helfen.
- showPaywall:
- false
- isSubscriber:
- false
- isPaid: